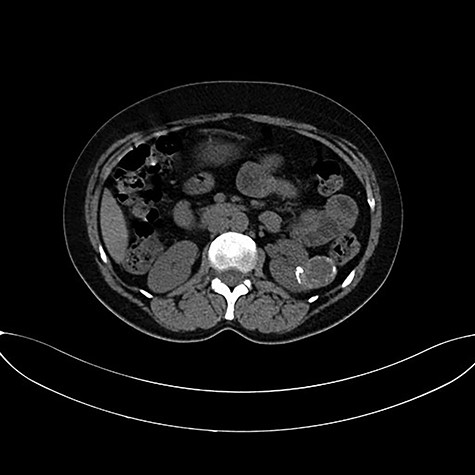

-
PDF
- Split View
-
Views
-
Cite
Cite
Irzi Mohamed, Mhanna Tarik, Aynaou Mohammed, Wassim Alaoui, Ouraghi Abdelghani, Barki Ali, Primary hydatid cyst looked like renal cell carcinoma: case report, Journal of Surgical Case Reports, Volume 2020, Issue 9, September 2020, rjaa231, https://doi.org/10.1093/jscr/rjaa231
Close - Share Icon Share
Abstract
Renal hydatid cyst is a rare disease comprising of about 2–3% of all locations. We present a case of renal hydatid disease in a 48-year-old female patient who presented with a history of left flank pain without fever or hematuria. Ultrasonography and computed tomography showed a 3-cm cystic lesion Bosniak IV occupying the mid-zone of the left kidney diagnosed as renal malignancy. Laparoscopic partial nephrectomy was performed, but the histopathological examination of the lesion revealed hydatid cysts. Isolated renal hydatid cyst is very rare, especially in developed countries and can be misdiagnosed as a renal cell carcinoma pre-operatively.
INTRODUCTION
Hydatid disease is mainly caused by Echinococcus granulosus. Humans acquire the infection when they become intermediate hosts of these tapeworms by accidental ingestion of the eggs of E. granulosus [1]. We report on a case of renal hydatid cyst taken as renal cell carcinoma and managed by laparoscopic partial nephrectomy.
CASE PRESENTATION
A 48-year-old Moroccan female from an urban area was admitted as an emergency for left flank pain that started 2 years ago. There was no history of hematuria, fever or pyuria. On clinical examination, there was a left flank tenderness. The patient was afebrile and appeared otherwise healthy. There were no abnormal pulmonary signs and no peripheral lymphadenopathy. Blood tests did not show eosinophilia.
Abdominal ultrasound and computed tomography showed a 3-cm cystic lesion occupying the mid zone of the left kidney with a thickened irregular wall, calcifications, partially contrast enhancement and without secondary locations. The right kidney and other organs were normal. This renal lesion was diagnosed as cystic renal cell carcinoma (Fig. 1).
Left transperitoneal laparoscopic partial nephrectomy was performed. In the semilateral position, the first port was created at the midline 3 cm above the umbilicus. Three additional ports were created under vision for trocars. Left renal cyst was exposed in the mid zone with careful renal dissection. The renal pedicle was isolated and temporarily clamped by laparoscopic bulldog. The renal cyst was removed without any spillage of the contents of the cyst or opening of the excretory tracts (Fig. 2). The renal parenchyma was closed using 0–0 Vicryl sutures. The specimen was sent for histopathological examination.

Anatomo-pathological examination revealed presence of a multilocular renal cystic lesion containing many hyaline acellular membranes. The cystic layer was made of a fibrotic tissue contain many inflammatory cells with cholesterol clefts (Figs 3 and 4).

Pathological examination revealed presence of a laminated; acellular and eosinophilic membrane with presence of many scolexes in the cystic lumen. (HE; 100X).

The scolexes showed presence of many hooklets that appeared refractile at microscopic examination (HE; 400X).
The patient was discharged on the third post-operative day with oral albendazole for 4 weeks. After 18 months of clinical and radiological surveillance, the patient was asymptomatic without any recurrence of the hydatid disease.
DISCUSSION
Hydatid disease is mainly caused by E. granulosus and transmitted from animals like dogs. Humans are an intermediate host by accidental ingestion of contaminated materials. Usual locations of hydatic disease are the liver and lung (90%). They can, however, reach any other organ. But, the solitary renal hydatid cyst is rare (2%) [1].
The clinical presentation of E. granulosus infection depends upon the site of the cysts and their size. Patients may be asymptomatic or symptomatic presenting with flank pain, hematuria or hypertension [2]. Hydatiduria is pathognomonic to the disease, but it is usually not present. Our case presented with flank pain.
Serology tests can be used to confirm imaging results [3]. Ultrasonography, computed tomography and magnetic resonance imaging are the imaging methods used for diagnosis and evaluation of the extent of hydatid disease. The typical aspect for renal hydatid cyst in ultrasonography and computed tomography is the simple cyst with floating membrane or multilocular cyst [4]. In our case, ultrasonography and tomography showed an atypical cyst Bosniak IV according to the modified Bosniak Classification of Cystic Renal Masses. MRI is useful in type IV, for differentiating between pseudotumoral hydatid cyst and cystic renal cell carcinoma, but it may be inconclusive [3].
In our case, laparoscopic partial nephrectomy was promptly performed, because the imaging was very suspicious for a malignancy. The surgical procedure was uncomplicated as the renal cyst was exophytic and small. The post-operative histopathological examination revealed the diagnosis of a hydatid cyst. Aggarwal et al. reported on the laparoscopic treatment of three cases with renal hydatid cyst using a special system known as the Palanivelu hydatid system. This system has a trocar with a dual channel: one for insufflation and the other for aspiration. The cannula system is used to avoid spillage of the contents of the cyst in the peritoneal cavity. In our case, the renal cyst was misdiagnosed as renal cell carcinoma and a partial nephrectomy was performed. The risk in this case was to perforate the cyst and induce a fatal anaphylactic shock. In the literature, many cases of isolated renal hydatid cysts being misdiagnosed have been reported and operated as renal tumors [5, 6]. The challenge is to avoid the spillage of the content of the cyst. The risk of spillage is very high especially in laparoscopy for misdiagnosed cysts [4].
Renal cell carcinoma is still a principal differential diagnosis especially in non-endemic area. However, it is safe to keep in mind that a renal cyst can be a hydatid cyst. Accordingly, safety instruments such as the Palanivelu hydatid system should be available in the laparoscopic armamentarium during the operations of complex renal cysts to avoid the potential risks of serious complications.
CONFLICT OF INTEREST STATEMENT
The authors declare they have no relevant interest(s) to disclose.